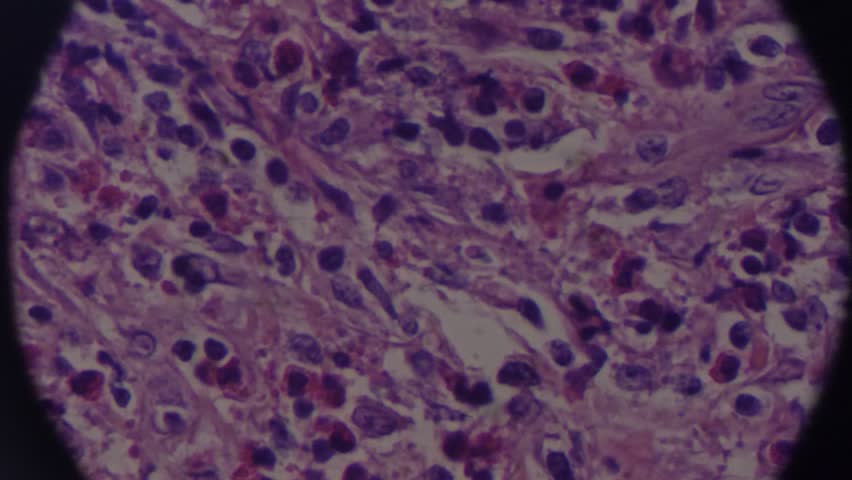

903 768
После обломова остается сын
Сп 64 13330 2019 деревянные
Что делать если болит колено лечение
Портрет разумихина
След от штампа на бумаге 6
Gussi coffee миргородская ул 20 отзывы
Студия vl
Кудин дорогая
Primal vs predator
Пресвятая богородица 7 апреля
Redmi 2201117ty модель
Vs czech
Участок в краснодаре многодетным семьям
903 768 100 фото